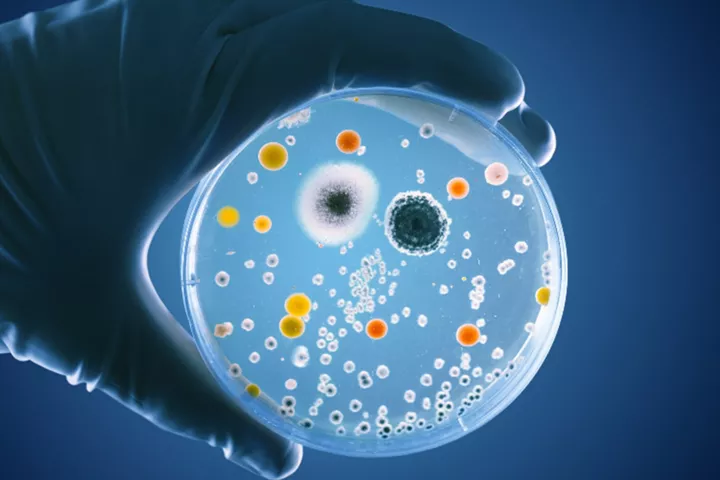
esrs studie für den chemiesektor

Studie: Praxis der Nachhaltigkeitsberichterstattung nach CSRD/ESRS
Eine Analyse börsennotierter Unternehmen für das Geschäftsjahr 2024/2025
In einem Kooperationsprojekt haben Deloitte und das Deutsche Rechnungslegungs Standards Committee (DRSC) eine empirische Studie zur Praxis der Nachhaltigkeitsberichterstattung nach CSRD/ESRS durchgeführt. Das Untersuchungsobjekt waren die Berichterstattungen börsennotierter Unternehmen des DAX, MDAX und SDAX für das Geschäftsjahr 2024/2025. Die Untersuchung klärte, inwieweit die Unternehmen nachhaltigkeitsbezogene Informationen gemäß der Bilanzrichtlinie (in der Fassung der CSRD) und der European Sustainability Reporting Standards (ESRS) veröffentlicht haben.
Report: Analyse für das Geschäftsjahr 2025
151 analysierte Berichte (veröffentlicht bis 30.04.2026) – inklusive Aufgliederung nach Indizes und Branchen
Studie: Praxis der Nachhaltigkeitsberichterstattung nach CSRD/ESRS
Laden Sie hier die Studie herunter: Eine Analyse von DAX-, MDAX- und SDAX-Unternehmen für das Geschäftsjahr 2024
„Unsere Studie erleichtert Unternehmen die Nachhaltigkeitsberichterstattung
nach ESRS, indem sie Hilfestellungen zur Bestimmung branchenspezifisch
wesentlicher Themen liefert. Ferner enthält sie detaillierte Einblicke und
Beispiele dafür, wie Unternehmen komplexe und auslegungsbedürftige
Berichtspflichten realistisch umgesetzt haben.“
(Dr. Matthias Schmidt)
Regulatorischer Hintergrund
Die durch die Corporate Sustainability Reporting Directive (CSRD) geänderte Bilanzrichtlinie wurde in Deutschland bislang nicht umgesetzt. Daher bestand für große Unternehmen von öffentlichem Interesse mit mehr als 500 Mitarbeitenden weiterhin die Verpflichtung, für das Geschäftsjahr 2024 eine nicht-finanzielle Erklärung bzw. Konzernerklärung abzugeben. Diese musste entweder in den Lagebericht/Konzernlagebericht eingebettet oder außerhalb davon veröffentlicht werden.
Die ESRS dürfen als europäisches Rahmenwerk zur Aufstellung einer nicht-finanziellen Erklärung/Konzernerklärung herangezogen werden. Unternehmen, die zur nicht-finanziellen Berichterstattung verpflichtet sind, können die ESRS somit ganz oder teilweise beachten oder aber gänzlich von ihrer Beachtung absehen.
ESRS-Konformität
Es hat sich gezeigt, dass die Mehrheit der Unternehmen „unter vollständiger Beachtung der ESRS“ berichtet hat. Dabei wurde festgestellt, dass größere Unternehmen (DAX-Unternehmen) deutlich häufiger vollumfänglich nach ESRS berichteten als kleinere (SDAX-Unternehmen). Knapp die Hälfte der analysierten Berichte wurde „in Anlehnung an die ESRS“ erstellt.

Durchschnittliche Seitenanzahl
Die Seitenanzahl der untersuchten Nachhaltigkeitsberichte beträgt im Durchschnitt 130, variiert aber stark – insgesamt liegt sie zwischen 29 und 313 Seiten. Im Indexvergleich zeigt sich, dass größere (DAX-)Unternehmen Berichte mit höheren Seitenumfängen (durchschnittlich 157) veröffentlicht haben als kleinere Unternehmen (MDAX: durchschnittlich 122, SDAX: durchschnittlich 104).

Wesentliche ESRS-Themen
Die ESRS-Themen „Klimawandel“ (ESRS E1), „Arbeitskräfte des Unternehmens“ (ESRS S1) und „Unternehmensführung“ (ESRS G1) wurden von fast allen der 77 Unternehmen als wesentlich identifiziert. Die ESRS-Themen „Wasser- und Meeresressourcen“ (ESRS E3), „Biologische Vielfalt und Ökosysteme“ (ESRS E4) sowie „Betroffene Gemeinschaften“ (ESRS S3) wurden dagegen von weniger als der Hälfte der Unternehmen als wesentlich eingestuft. Im Durchschnitt haben die analysierten Unternehmen sechs ESRS-Themen als wesentlich bewertet, wobei die Anzahl insgesamt zwischen drei und zehn wesentlichen ESRS-Themen variiert.

Anzahl identifizierter IROs (Impacts, Risks, Opportunities)
Im Durchschnitt wurden 43 IROs (16 negative Auswirkungen, zwölf positive Auswirkungen, fünf Chancen und zehn Risiken) identifiziert, wobei die IRO-Anzahl in einer Bandbreite von sechs bis 118 IROs je Unternehmen liegt. Darüber hinaus zeigt sich, dass hierbei die Risiken und negativen Auswirkungen von höherer Bedeutung waren als die Chancen und positiven Auswirkungen. Ein Vergleich nach Indexzugehörigkeit zeigt, dass MDAX-Unternehmen mit insgesamt 53 IROs im Durchschnitt die meisten wesentlichen IROs identifizierten, gefolgt von DAX-Unternehmen mit 44 IROs und SDAX-Unternehmen mit 34 IROs.

Prüfung des Berichts
Von den 77 Berichten wurden knapp drei Viertel mit begrenzter Sicherheit und ein Bericht vollständig mit hinreichender Sicherheit geprüft. Etwa 20 Prozent der 77 Unternehmen haben einzelne Angaben mit hinreichender Sicherheit prüfen lassen. Sechs Berichte wurden keiner Prüfung unterzogen. Alle Prüfungen der untersuchten Berichte wurden von Wirtschaftsprüfer:innen durchgeführt und führten zu uneingeschränkten Prüfungsurteilen.

Weiterführende Informationen
Wir stehen Ihnen darüber hinaus für weitere Rückfragen zu unserer Studie zur Verfügung. Kontaktieren Sie hierfür gerne jederzeit unsere Ansprechpartner:innen.
Download-Bereich: Übersicht über die bisherigen Veröffentlichungen
Aktuelle Studie herunterladen
Die Praxis der Nachhaltigkeitsberichterstattung nach CSRD/ESRS für das Geschäftsjahr 2024